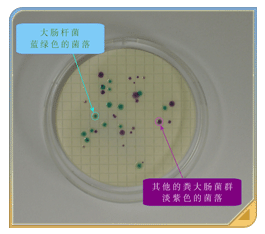

| 监测泳滩水质 |  |



| 现行的海水抽样和实地量度水质 (左),对比1990年代(中)和1980年代(右) |
环保署定期在香港的泳滩抽取水样本测试。宪报公布的泳滩在泳季每月最少抽样三次,其它月份亦每月最少抽样一次,至于个别全年开放的宪报公布泳滩则一年四季每月最少抽样三次。
虽然我们经常抽取海水样本,但没有硬性的时间表,环保署人员可在一周内选择任何一天进行抽样工作,包括周末及公众假期,这是因为按照硬性时间表抽取海水样本可能会错过经常在个别日子(例如逢周末)才出现的重要趋势或事故,而在一周内弹性地选择日子抽样则可监察到这类情况,为我们提供更全面的泳滩水质数据。

|
环保署督察抽取海水样本时,需从离岸不远处水深及大腿至腰的水域抽取样本。样本在进行测试前须储存于摄氏4度低温下。我们的督察除了抽取海水样本,还会检视泳滩附近的河溪或排水渠并抽取水样本检验是否有污染情况。
环保署督察抽取水样本时,亦会利用电子手帐(PDA)输入其它有关数据,包括水温、海水含氧量、当时的天气状况和其它泳滩水质和环境数据。数据输入PDA后,可轻易地在环保署办事处直接载入服务器以便分析。

|
1987年,环保署自设环境微生物学化验室,负责分析收集所得的泳滩海水样本,弃用以往的「多管法」,改用经过改良的薄膜过滤法(Membrane Filtration Method)分析样本,取得更准确的检测结果。这套分析方法一直沿用至今,但培养大肠杆菌的介质媒体则在1997年进一步改良,采用可发色体培养基(CLECC),报告时间亦由3天缩短至1.5天。
泳滩海水样本抽取6小时内,须送抵环保署化验室进行大肠杆菌含量测试。目前采用的薄膜过滤法是以滤膜隔滤海水中的细菌,然后将滤膜放到特殊的培养基上,在摄氏44.5度的有氧环境下培养18至24小时,其间滤膜表面隔滤的细菌会形成独特的蓝绿色斑点(大肠杆菌菌落)。这些菌落的数量代表细菌的数量。此外,化验人员并会量度海水样本的酸碱值、盐度和混浊度。
多年来,环保署多次改进和精简样本的采集和细菌的测试,确定了此项工作的可靠性和良好的科学基础。